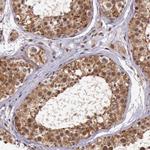
ARMX3 Antibody in Immunohistochemistry (Paraffin) (IHC (P))

Search
Invitrogen
ARMX3 Polyclonal Antibody
{{$productOrderCtrl.translations['antibody.pdp.commerceCard.promotion.promotions']}}
{{$productOrderCtrl.translations['antibody.pdp.commerceCard.promotion.viewpromo']}}
{{$productOrderCtrl.translations['antibody.pdp.commerceCard.promotion.promocode']}}: {{promo.promoCode}} {{promo.promoTitle}} {{promo.promoDescription}}. {{$productOrderCtrl.translations['antibody.pdp.commerceCard.promotion.learnmore']}}
产品信息
PA5-51493
种属反应
宿主/亚型
分类
类型
抗原
偶联物
形式
浓度
规格
纯化类型
保存液
内含物
保存条件
运输条件
RRID
产品详细信息
Immunogen sequence: SAGNEETKLQ VLKLLLNLAE NPAMTRELLR AQVPSSLGSL FNKKENKEVI LKLLVIFENI NDNFKWEENE PTQNQFGEGS LFFFLKEFQV CADKVLGIES HHDFLVKVKV GKFMAKLAEH M
Highest antigen sequence identity to the following orthologs: Mouse - 91%, Rat - 89%.
靶标信息
This gene encodes a member of the ALEX family of proteins which may play a role in tumor suppression. The encoded protein contains a potential N-terminal transmembrane domain and a single Armadillo (arm) repeat. Other proteins containing the arm repeat are involved in development, maintenance of tissue integrity, and tumorigenesis. This gene is closely localized with other family members on the X chromosome. Three transcript variants encoding the same protein have been identified for this gene.
仅用于科研。不用于诊断过程。未经明确授权不得转售。
篇参考文献 (0)
生物信息学
蛋白别名: ARM protein lost in epithelial cancers on chromosome X 3; arm protein lost in epithelial cancers, X chromosome, 3; Armadillo repeat-containing X-linked protein 3; binds SH3 domain of non-erythroid alpha-spectrin; DKFZp781N1954; KIAA0443; MGC12199; Protein ALEX3; unnamed protein product
基因别名: ALEX3; ARMCX3; BM-017; dJ545K15.2; GASP6; UNQ2517/PRO6007
UniProt ID: (Human) Q9UH62
Entrez Gene ID: (Human) 51566